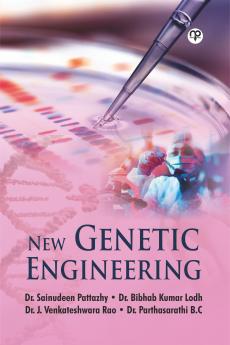
NEW GENETIC ENGINEERING

English
Hardback
₹714
₹995
28.24% OFF
(All inclusive*)
Delivery Options
Please enter pincode to check delivery time.
*COD & Shipping Charges may apply on certain items.
Review final details at checkout.
Looking to place a bulk order? SUBMIT DETAILS
About The Book
Description
Author
Genetic engineering stands as one of the most transformative and revolutionary fields in the history of science. Its roots extend deep into the annals of biology and genetics with a rich history spanning centuries. From the earliest observations of inheritance to the modern era of precision gene editing the journey of genetic engineering is a remarkable narrative of innovation experimentation and profound scientific discovery
Delivery Options
Please enter pincode to check delivery time.
*COD & Shipping Charges may apply on certain items.
Review final details at checkout.
Details
ISBN 13
9789355453426
Publication Date
-30-09-2023
Pages
-309
Weight
-509 grams
Dimensions
-152.4x228.6x17.93 mm